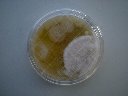
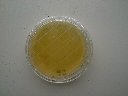
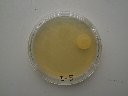

第1回「e−食安全研究会」実践講習会
食品調理、加工作業とHACCP
〜HACCPの基本的概念に基づく調理、加工作業の体得実践〜


「スタンプ法」で実際に参加者の皆さんの手指や、実習室の床、調理台の上などの微生物を採取してもらいました。その結果を以下にご紹介します。
なお、初歩的なミスですが、運送途中に天地が逆になってしまい、培地がフタにくっついて結果が判別できないものがあります。裏から撮影したものもありますが、何卒ご了承ください。結果を楽しみにしてくださっていた参加者の皆様、申し訳ございません。
※培養時間 35℃ 2日間
●A2〜N2:下処理室、検収室(=汚染作業区域)の床
|
A2
|
B2
|
C2
|
D2
|
E2
|
|
F2
|
G2
|
H2
|
I2
|
J2
|
|
K2
|
L2
|
M2 |
N2
|
Z2
|
*各画像をクリックすると大きい画像が見られます。
●A3〜N3:手洗い前の手指
|
A3
|
B3
|
C3
|
D3
|
E3
|
|
F3
|
G3
|
H3
|
I3
|
J3
|
|
K3
|
L3
|
M3 |
N3
|
Z3
|
*各画像をクリックすると大きい画像が見られます。
●A4〜G4:水道水で手洗い後の手指
H4〜N4:洗浄剤で手洗い後の手指
H4〜N4:洗浄剤で手洗い後の手指
|
A4
|
B4
|
C4
|
D4
|
E4
|
|
F4
|
G4
|
H4
|
I4
|
J4
|
|
K4
|
L4
|
M4 |
N4
|
Z4
|
*各画像をクリックすると大きい画像が見られます。
|
A5
|
B5
|
C5
|
D5
|
E5
|
|
F5
|
G5
|
H5
|
I5
|
J5
|
|
K5
|
L5
|
M5 |
N5
|
Z5
|
 |
*各画像をクリックすると大きい画像が見られます。